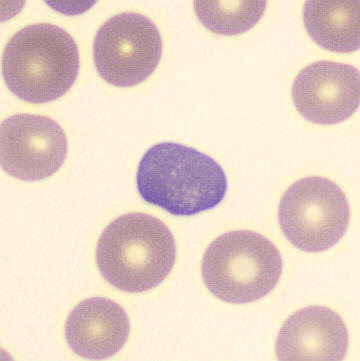
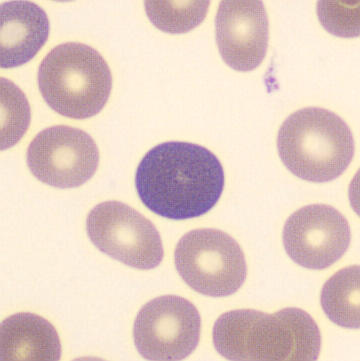
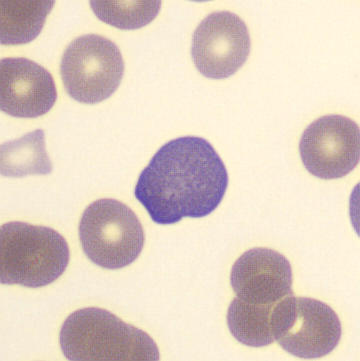

RET - Reticulocytosis
FSC
SFL
Erythrocytes
Reticulocytes
RBC fragments
The erythrocyte population shows an additional diffuse horizontal population from the center. Reticulocytes have a higher fluorescence signal than mature erythrocytes because their RNA reacts with the WNR reagent. Mature erythrocytes contain no RNA.
Reticulocytosis is an increase in the number of reticulocytes in the peripheral blood and reflects increased erythropoietic activity of the bone marrow. It usually occurs in response to anemia, such as in acute bleeding or hemolysis, but may also be seen during recovery after treatment for iron, vitamin B12 or folate deficiency. In addition, reticulocytosis may occur after recovery from bone marrow suppression or after erythropoietin administration. The degree of reticulocytosis often gives an impression of the regenerative capacity of the bone marrow.
Possible morphology

In a blood smear, reticulocytes can sometimes be recognized as polychromatic erythrocytes. Normochromatic erythrocytes can also be reticulocytes.








































